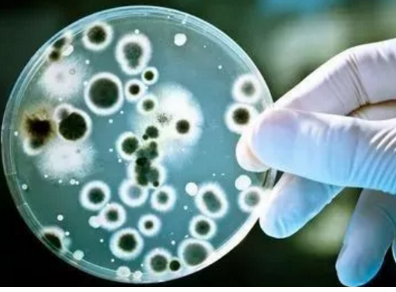
blob.png

Elektroonilised tooted, nagu mobiiltelefonid, arvutid ja tahvelarvutid, on muutunud igapäevaelu lahutamatuks osaks. Me ei saa seda alati jätta. Täna räägime neist mobiiltelefonidest ...
Aastal 2016 avaldas eMarketer uuringu, mille mobiilseadmete uuringute aruanne näitab, et kasutajad veedavad oma mobiilseadmetes 4 tundi ja 5 minutit päevas. Konservatiivide hinnangul kasutame telefoni rohkem kui 150 korda päevas! Veelgi enam, see arv kasvab endiselt.

Kasutame mobiiltelefone iga päev, kasutage seda äratusena hommikul ja meelelahutuseks öösel, kuid paljud ei tea telefoni tervist. Vastavalt Lõuna-Korea kormedi veebisaitide aruandele on viimaste uuringute tulemused näidanud, et mobiiltelefoni bakterid on palju rohkem kui inimesed, isegi 10 korda määrdunud kui tualeti kaas.
Ühendkuningriigi Deloitte Consulting Company'i uuringu kohaselt vaatavad inimesed päevas keskmiselt 47 mobiiltelefoni, mille jooksul mikrofonid jäävad mobiiltelefoni. Tartu Ülikoolis leiti, et keskmine bakteri geenide arv igas telefonitoruosas oli rohkem kui 17 000.
Kõne ajal hõivatakse neid baktereid näo ja teiste kehaosadega, põhjustades akne, kopsupõletikku, meningiiti ja muid haigusi. Nende hulgas võivad Staphylococcus aureus ja Escherichia coli põhjustada isegi hingamisteede haigusi ja põhjustada kõhulahtisust. Tavaliselt aga ei ole tavatarbijatel mobiiltelefonid teadlik.

Nüüd sisesta musta tehnoloogia aeg!
Meie loodusmaailmas on palju aineid, millel on head bakteritsiidsed või mikroobsed inhibeerivad funktsioonid. Neid nimetatakse antibakteriaalseteks aineteks. Need on jagatud anorgaanilisteks antibakteriaalseteks aineteks, looduslikeks antibakteriaalseteks aineteks ja sünteetilisteks antibakteriaalseteks aineteks.
Loomulikult ei ole meil mobiiltelefonides otseselt võimalik neid elusaid antibakteriaalseid aineid lisada. Täna räägime antibakteriaalsete materjalide loomiseks kasutatavate teaduslike ja tehnoloogiliste vahendite kasutamisest.
Põhimõte: teatud koguses antibakteriaalse aine lisamine materjali võib muuta materjali võime pinnakatteid pärssida või tappa.
Tänapäeval sisaldavad antibakteriaalsed materjalid peamiselt antibakteriaalseid plastikke, antibakteriaalseid kiude ja kangasid, antibakteriaalset keraamikat ja antibakteriaalseid metalli materjale, millest enim levinud antibakteriaalseid plastikke on laialdaselt kasutatud köögitarvete, kodumasinate, meditsiini ja tervise valdkonnas. ulatuslikum kasutamine.
Kuid plastikust elektrooniliste toodete suur osakaal pole veel antibakteriaalset plastikut rakendanud, mistõttu?
Originaal, mobiiltelefonid ja muud elektroonikaseadmed jätkavad valgustamist, et hõlbustada igapäevast vedu. Samal ajal peavad mobiiltelefonid olema ka kõrgete mehaaniliste omadustega, eriti kukkumise korral, ei saa hävitada. See on mobiiltelefoni materjali tugevuse mõju, mis esitab kõrgeid nõudeid.
Kui lisate antibakteriaalseid aineid plastikmaterjalides, põhjustab see tihti languse füüsikalisi omadusi. Plastmaterjalide füüsikalised omadused pärast langust ei suuda vastata elektrooniliste toodete nõuete rangele valikule. Seepärast on mikroobivastaseid materjale elektroonikatootetel raske kohaldada, kui nad ei suuda lahendada antibakteriaalsete ainete lisamise põhjustatud füüsikaliste omaduste vähenemise probleemi.
Õnneks
Toormaterjalide kujundamise kaudu on välja töötatud antibakteriaalsete ainete valik ja töötlemistehnoloogia parandamine, mobiiltelefonidele ja arvutitele pakutavad antibakteriaalsed plastid. Sealhulgas antibakteriaalne leegiaeglustav PC / ABS, antibakteriaalne leegiaeglustaja PC, antibakteriaalne leegiaeglustajana klaaskiust tugevdatud PC.
Leegiaeglustav arvuti on praegu turul rohkem plastmaterjale, ja siis, kuidas pärast seda, kui proovime lisada antibakteriaalset leegiaeglustavat PC-d.

Võrdlustesti abil näeme selgelt, et mikroobivastane leegiaeglustav PC-materjal ei vasta mitte ainult elektrooniliste toodete füüsilistele nõuetele, vaid ka suurepärastele antibakteriaalsetele omadustele. Lisaks sellele viidi läbi materjali antibakteriaalsete omaduste edasiseks kontrollimiseks võrdluskatse nende kahe materjali bakterikultuurist.

Eksperimentaalne kirjeldus: Escherichia coli liik, vastavalt JIS Z 2801 (vastab standardile ISO 22196), määravad kontrollrühma.
Antibakteriaalse efekti nägemise hõlbustamiseks on logaritmi väärtus (Log väärtus). Kontrollgrupp kaotas eksperimentaalrühma väärtuse, oli antimikroobne toime, viimane logiväärtus seni, kuni suurem kui 2 on 99% antimikroobne toime (antibakteriaalse testi abil).
Eksperimentaalsed tulemused Me näeme, et tabeli antibakteriaalne toime saavutas 3,8, st umbes 99,99% antibakteriaalsest toimest. Ja tasub märkida, et sellel materjalil on püsiv antibakteriaalne aine.
Järeldus: tulemuslikkuse seisukohast võib uus antimikroobne materjal täielikult vastata mobiiltelefonile, iPadile ja muudele elektroonilistele toodetele, materjalinõuetele, kuid ka püsivale antimikroobsele ainele ning seda saab kasutada laste mobiiltelefonide, laste arvutite jaoks. Kõrgete kulude tõttu on rakendus endiselt piiratud. Siiski on prognoositav, et materjalide pideva arengu tõttu vähenevad kulud järk-järgult. Antibakteriaalsed mobiiltelefonid ja antibakteriaalsed arvutid sisenevad lõpuks igapäevaelu ja tagavad meie tervise kaitse.